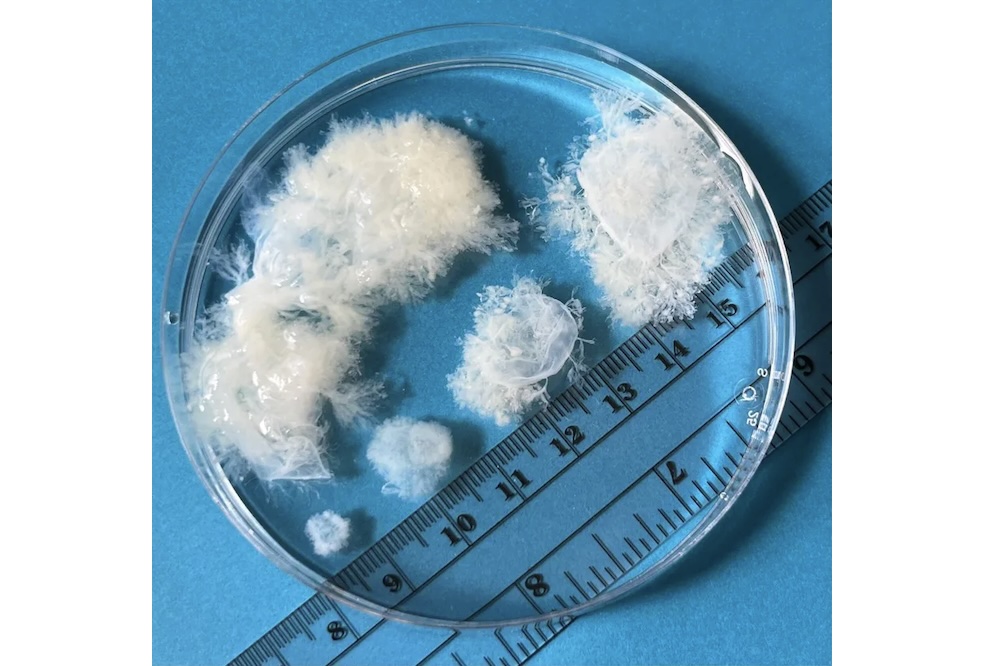
Our Visuality: Abortion Care Work and Photography

Amid a surging wave of political activism and newly liberated energies, Carolee Schneemann wrote, in 1968, that “perception should lead to action.” Schneemann suspected that awareness would only go so far. So in the interest of yielding some profound action from the emerging consciousness surrounding sex and war, she set about aestheticizing both.
Throughout her career, Schneemann’s imperative has tended to induce a discomfort that occasionally boils over into outrage. When her now-infamous 1965 film, Fuses, was shown at Cannes in ‘68, she recounts that about 12 or 15 men lost it completely. They started screaming and ripping up the theater seats with razors. The film showed Schneemann making love to her then-partner, the composer James Tenney, their sexual intimacy intercut with scenes of domestic life and car rides in the changing seasons of their upstate home. It was all too much for an audience unaccustomed to the directness of her provocations.
Her treatment of war imagery – a painterly embellishment of horrific pain and suffering – has proved as provocative. When she showed Terminal Velocity in New York in December of 2001, the work was seen as exploitative, obscene, irreverent, cruel. Boldly, lyrically arranged in vertical columns were black-and-white images of bodies, close up, falling to their deaths from the Twin Towers. In his essay, “Revolt, She Said,” David Levi Strauss recounts that Schneemann ignored his advice against showing this work so soon. “My point was that the wound was too fresh, the trauma too recent to allow effective treatment, but for Carolee, that was the right time. ‘Going too far’ is a tried and true therapeutic principle, as well as an aesthetic and ethical one.”

But it’s worth asking: how is it that certain images like Schneemann’s are perceived as going “too far.” It goes beyond the voyeuristic overtones of her zoom, the singling out of bodies. In her recently published anthology Uncollected Texts (2018), edited by Branden Joseph, Schneemann takes issue with the term “use” – an orientation toward material that could be at the root of this negative reaction, building around a suspicion that Schneemann is using this sensitive material in her work to sensational effect:
USE just doesn’t answer or serve my relationship to people and objects… Brakhage, Kluver, and others say that they are interested only in what they can ‘use’. The tone is not towards ‘partaking’ but ‘to convert to one’s service’, to consume and exhaust … I say, ‘I use materials’, but I often sense that they use me as vision from which they re-emerge in a visual world which could not speak without them.
If these images of falling bodies were “using” Schneemann, and not the other way around, it was perhaps to channel a collective grief that needed tending. Strauss notes her conviction that “to treat traumas in the whole social body and psyche, it is sometimes necessary to push things toward a healing crisis … The time to treat the wound is when the wound is open and fresh.” But our history of repression runs deep, and when we deem something an “irreverent” treatment of grief, we should look to the ideological ground in which our notions of reverence took root. In 589 AD, sixty-two bishops gathered for The Third Council of Toledo to plot the eradication of grief (a process which has persisted since under various ingenious guises). It became illicit to publicly grieve one’s losses throughout Europe at the onset of Christianity, such unseemly displays of emotion being cast as a failure of faith in the will of God.
Francis Weller writes in The Wild Edge of Sorrow, “Grief is suffused with life force. It is riddled with energy, an acknowledgement of the erotic coupling with another soul, whether human, animal, plant, or ecosystem … Grief is alive, wild, untamed … It resists the demand to remain passive and still. We move in jangled, unsettled, and riotous ways when grief takes hold of us.” Given its subversive, soul-nourishing power, it’s little wonder that those vying for religious and social control aimed to outlaw grief.
Of course, the attack on the Twin Towers did precipitate forms of public grieving. The streets did fill with jangled, unsettled souls and improvised grief shrines: hopeful glimpses of a collective will to mourn. Yet Schneemann’s images remain suspect – the aestheticization is difficult to overcome. Worse still, she layered paint on top of the falling bodies of Terminal Velocity, reconfigured them, and titled the result Dark Pond, a piece that was included in her recent MoMA PS1 retrospective (Oct 2017 – March 2018). The figures in this work are both obscured and framed by washes of red and green, squiggles of yellow, black, and blue. The curating of Schneemann’s work at PS1 interspersed Dark Pond, as well as other political works, with pieces of a more sexual and personal nature. To be scandalized by this arrangement is, I think, to assume that sensualizing is sensationalizing – that it renders its subject trivial and shallow. We are entrained, in subtle ways, to the notion of the senses as a frivolous addendum to the crystalline reality of the mind.
Insisting on foregrounding the sensory and corporeal, Schneeman bookended her PS1 exhibition with a screening of Fuses, inducing arousal in her viewers, who then proceeded to move through a jolting admixture of personal and political work.. Perhaps her most infamous mingling of sex and violence is another 1965 film, Viet-Flakes, in which collaged images of the Vietnam War swim in and out of focus, and are set to a ghostly soundtrack of 60s radio pop, folk, and classical music, as well as the sound of orgasm. This injection of erotic material into a horror-scape of violence is driven not by a disregard for the seriousness of war, but a conviction in the seriousness of sex. “Cut off from their own essential natures,” Schneemann remarks of a people disconnected from their sexuality, “they are incalculably dangerous.” For Schneemann, eros is a guiding force by which we might ethically orient ourselves, and a people harnessing it might happily do away with bishops, in their many and ever-present forms.

In Uncollected Texts Schneemann describes the choreographic logic of her performances. They should proceed, she writes, according to an “organic necessity,” a state of fluid collaboration uniting bodies within a collective, pulsating intelligence. Cultural ecologist David Abram has written at length about the gradual atrophy of our ability to dwell and act in the sensuous world. In a recent essay, “Creaturely Migrations on a Breathing Planet,” he describes the dance of migratory animals with a language that echoes Schneemann’s choreographic ideals. He evokes the “collective visceral imperative” of salmon thrusting their bodies upstream to their spawning site, the Monarch butterfly’s journey northward that unfolds over the course of three generations. “These beings are dancing,” he writes, “not with themselves but with the animate rondure of the Earth, their wider Flesh.” He speculates that their nervous systems are connected by sense experience to their environment, and laments that as humans have inserted more and more tools between our bodies and the living land, we have lost “the spontaneous reciprocity between our senses and the earthly sensuous,” navigating the world as isolated individuals rather than as organs within the larger body of the Earth.
Schneemann expressed a kindred lament when she wrote in 1966 of our “icy psychic technological ‘cool’,” and again when she noted the following year that our inventions curtail our perception, that we are blocked off from the earth’s “quivering and shining” by the “mechanical labyrinths” of the city. When it comes to mechanical objects, she wants the guts visible, enjoying them not for their ability to substitute human action, but for the illicit, disavowed fact of their own texture. In her Dust Series (1980s), circuit boards are laid bare and pinned to the canvas, caught up in a field of dense activity and earthy color, their presence competing with dynamic globs of paint, sprinkles of glitter, pasted feathers.

In his strange 1980 “photography” book, Camera Lucida, Roland Barthes famously entreats his reader to allow herself to be wounded again by the image. He saw the photographic image totalizing our engagement with the world, warning that it “completely de-realizes the human world of conflicts and desires, under cover of illustrating it.” Schneemann’s work reminds us of our resistance to the wound. Sex and death appear as cheap spectacle only when we are numb to the persistent strain of wildness that arousal and tears call forth. The suppressed flows of grief and sexuality – waterways of our psycho-somatic being – swell at the dams that bolster civilized society. This greater body becomes stiff and immobile, losing the flexibility that would inform rhythmic intelligence.
We are exhausting the fantasy that if humans know what is true – about the horrors of war, about the earth’s bruised and battered body – they will, en masse, do something about it. For some, the response has been a defeated withdrawal from the world of “activism.” However when Schneemann writes that “perception should lead to action,” she doesn’t mean that we should see, and then know, and then devise an appropriate response. This approach suffers from our overly cerebral filtering of the world, our routine by-passing of the body’s other ways of knowing. “Action” and “perception” in Schneemann’s formulation are two intimately entwined modes of the same gesture, a gesture as sure and inspired as the salmon throwing her small, heavy body upstream.

Contribute your thoughts by leaving a reply